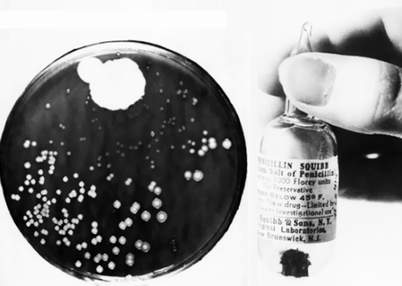

Có một số phát minh và khám phá khoa học cực kỳ độc đáo trong thời đại của chúng ta không phải được hình thành từ bộ óc của một thiên tài mà là xuất phát từ một tai nạn mang tính ngẫu nhiên. Trong nhiều trường hợp, những phát minh này làm thay đổi diện mạo của những ngành công nghiệp chủ chốt hoặc sáng tạo ra một lĩnh vực mới.
Thuốc kháng sinh penicillin
Trở về nhà sau một chuyến đi nghỉ mát vào năm 1928, Alexander Fleming, một nhà vi khuẩn học người Scotland, đã ngạc nhiên khi phát hiện ra rằng lớp meo đã mọc trên một số mẻ cấy vi khuẩn staphylococcus mà ông đã để ra không khí. Thứ meo vi khuẩn này được Fleming đặt tên là penicillium Notatum, có khả năng tiêu diệt các vi khuẩn gây hại. Cho mãi đến năm 1940, các nhà khoa học tại trường Đại học Oxford cuối cùng đã tìm ra cách "tách" penicillin thành công và phát triển nó thành thuốc kháng sinh đầu tiên.
|
Thuốc kháng sinh penicillin. |
Máy điều hoà nhịp tim cấy ghép
Những thiết bị máy điều hoà nhịp tim đầu tiên được sử dụng dòng điện xoay chiều, và những thiết bị này được treo trên tường, hơi bất tiện vì giường bệnh nhân bị mắc bệnh tim phải kê gần sát tường. Mọi chuyện đã thay đổi vào một buổi chiều của năm 1958, khi Wilson Greatbatch, một kỹ sư ở Buffalo, New York (Mỹ), đang cố gắng trong việc chế tạo ra máy tạo dao động nhằm ghi âm thanh của nhịp tim đập. Tuy nhiên, trong lúc chế tạo, Greatbatch đã nhầm lẫn trong việc treo cái điện trở, khiến dòng diện bị đảo chiều, nhưng lại ghi rõ cảm nhận tiếng tim đập trên cơ thể người. Greatbatch ngạc nhiên vì kết quả thử nghiệm khá kỳ quặc, ông đã gặp gỡ William Chardack, người đứng đầu khoa mổ tại một bệnh viện gần đó nhằm giúp đỡ. Tại bệnh viện nơi Chardack đang làm việc, Greatbatch đã thử nghiệm thiết bị mới của mình trên một con chó và nhảy cẫng lên vì vui mừng khi máy điều hoà nhịp tim đã ghi chính xác nhịp tim đập, thử nghiệm này diễn ra vào năm 1959, trở thành người đầu tiên trên thế giới chế tạo thành công chiếc máy điều hoà nhịp tim có thể cấy dưới da người.
Màu hoa cà
Đôi khi các nhà khoa học lại vô tình khám phá ra những thứ nằm ngoài đề tài khoa học, trường hợp đó thuộc về nhà hoá học người Anh tên là William Perkin. Giấc mơ lớn nhất đời ông là tìm ra phương pháp chữa trị dứt điểm căn bệnh sốt rét. Vào năm 1856, Perkin thử nghiệm trên một dạng thuốc ký ninh nhân tạo, sau khi thử nghiệm ông đã thu về một loại cặn đặc có màu đen. Đó là một kết quả dễ làm thất vọng, nhưng thay vì ném cái cặn đen kia đi, Perkin đã tỉ mỉ quan sát màu sắc của nó. Thực sự, lớp cặn không phải đen mà là nó có màu tím, mà màu tím cũng là thứ màu khá ưa chuộng trong y phục thời trang thời kỳ đó. Perkin đã tách chất màu tím trong cặn để sản xuất ra một chất màu hoa cà và xem nó là một loại phẩm nhuộm. Năm 1857, Perkin đã được cấp bằng phẩm màu nhân tạo, đây cũng là loại phẩm màu nhân tạo đầu tiên của loài người, sau đó Perkin mở một công ty chuyên bán loại phẩm màu hoa cà này.
Kem que
Mọi trẻ em trên thế giới đều tự hào bởi phát minh ngẫu nhiên của Frank Epperson. Vào năm 1905, Epperson mới 11 tuổi, có một lần cậu đã gặp tai nạn khi vô tình làm đổ một dạng chất lỏng có độ dính, rớt ngay trước cổng vào ngôi nhà của cậu ở San Francisco (Mỹ). Tai nạn xảy ra vào một đêm giá lạnh, ngày sau đó, cậu bé nhìn thấy cái tách đựng chất lỏng bị đổ hôm qua đã bị đông cứng lại thành que. Trong lúc đó, Epperson không hề có suy nghĩ gì về hiện tượng này thì gần 2 thập niên sau đó, ông đã được cấp bằng "tuyết đóng thành kem trên que" và gọi chung là Eppsicle, nhưng sau đó Eppsicle đổi tên thành "Popsicle" (kem que) do bởi trẻ em thích tên gọi này hơn. Vài năm sau đó, Frank Epperson bán lại phát minh của mình cho Công ty Joe Lowe ở thành phố New York (Mỹ). Ngày nay, kem que đã trở nên thông dụng với mọi người trên toàn thế giới, ước tính có hơn 30 hương vị kem que đang được ăn hàng ngày.
Lò vi sóng
Vào năm 1946 kỹ sư Percy Spencer của hãng Raytheon đã thử nghiệm Manhêtrôn - một dạng thiết bị có khả năng thoát ra bức xạ sóng vi ba - và ông cảm nhận rằng thỏi kẹo đựng trong túi áo đã bị tan chảy. Lập tức ông hiểu ra rằng Manhêtrôn có thể tương tác với các vật thể và sinh ra các hiệu ứng. Để chắc ăn, ông đã cho nấu một quả trứng, nó phát nổ. Mặc dù tai nạn, nhưng ông cũng hiểu rằng năng lượng lò vi sóng có thể làm chín thức ăn rất nhanh chóng. Spencer và các kỹ sư khác bèn bắt đầu phương án sử dụng tia sóng bức xạ này để ứng dụng cho các công dụng khác nhau. Vào năm 1947, thiết bị lò vi sóng đầu tiên trên thế giới đã ra đời, nó nặng khoảng 750 cân Anh, giá chỉ vài đôla, đến năm 1975 lò vi sóng đã được sản xuất đại trà và trở nên phổ biến.
 |
Lò vi sóng. |
Thuốc nổ Dinamit
Alfred Nobel, người thành lập nên giải thưởng Nobel danh giá mang tên ông. Vào thập niên 1860, nitroglycerin là một dạng thuốc nổ rất phổ biến, nhưng nó không bền. Cũng như không dễ dàng cho bất kỳ ai xử lý thứ chất nổ này. Nobel làm chủ một nhà xưởng sản xuất nitroglycerin, ông biết rằng thứ chất nổ nguy hiểm này cũng có thể "kiểm soát" cho nó an toàn hơn, vì thế ông bắt tay vào thực nghiệm. Một ngày nọ, khi nghiên cứu chất nổ trong phòng thí nghiệm, Nobel đã vô ý làm rớt một cái lọ ngay trên nền nhà. May quá, lọ không phát nổ, ông nhận ra nguyên do là bởi vì khi rớt, nước thuốc trong cái lọ đã ngấm qua mùn cưa. Từ một tai nạn nhỏ nhưng đã phút chốc trở thành một ý tưởng lớn trong việc tạo ra nitroglycerin an toàn hơn. Nobel đã kết hợp đất tảo cát - một dạng silic - và thuốc nổ, từ đây bắt đầu hình thành quy trình sản xuất dinamit trên quy mô lớn.
Teflon
Roy Plunkett, một nhà hoá học tại DuPont và cộng sự của ông là Jack Rebok, đã bắt tay nhau để phát triển một chất làm lạnh chlorofluorocarbon (CFC) mới bằng cách sử dụng tetrafluoroethylene (TFE) vào năm 1938. Bằng cách pha trộn TFE và axit hydrochloric và đặt chúng vào trong một cái hộp nhỏ rồi để khô tự nhiên qua đêm. Vào ngày kế tiếp, lạ chưa không sao mở nắp hộp được, khi nhìn vào khe hộp, Plunkett thấy cái hộp chỉ còn lại một nửa, họ khám phá ra rằng khí gas có trong hộp đã chuyển hoá thành một dạng lỏng, màu trắng trông như bột tuyết. Plunkett đã thử nghiệm một loại pôlime mới và nhận thấy rằng nó có khả năng đề kháng hơi nóng. Nó có khả năng chống kết dính hiệu quả. Với khám phá này, Plunkett đã nhận được bằng phát minh vào năm 1941, chất khám phá được đặt tên là Teflon vào năm 1944.
Thép không gỉ
Chiếc nĩa mà bạn hay dùng để xiên thức ăn hàng ngày là sáng tạo của Harry Brearley - một nhà luyện kim người Anh. Tuy nhiên, thép không gỉ không phải hoàn toàn là công trình khoa học của Brearley, vì những nhà luyện kim trong gần một thế kỷ trước ông đã thử nghiệm với nhiều hỗn hợp kim loại khác nhau, nhằm tạo ra những dạng kim loại không bị ăn mòn. Nhưng chưa ai từng thành công cho mãi đến khi Brearley chế tạo thành công vào năm 1913. Ông đã thuê một vài nhà sản xuất vũ khí, những người này chuyên chế tạo nòng súng, tham gia vào việc phát triển ra một loại hợp kim có khả năng chống lại sự ăn mòn. Brearley đã cho thử nghiệm nhiều yếu tố khác nhau vào các phần kim loại cho đến khi ông đã tạo ra một loại thép có chứa 12,8% chromium và 0,24% carbon. Có người cho rằng trong sản phẩm thép không gỉ ngoài hai thành phần kể trên, Brearley còn cho thêm axit nitric. Kết quả, hợp kim thép không gỉ có khả năng đề kháng cao ngay cả với nước chanh, Brearley còn khám phá ra rằng thép không gỉ sẽ là kim loại hoàn hảo cho việc làm ra dao kéo.
 |
Thép không gỉ. |
NHỮNG THÍ NGHIỆM ĐIÊN RỒ
Phải thừa nhận rằng, thí nghiệm và thử nghiệm là một bước bắt buộc quan trọng không thể bỏ qua trong việc đưa nhân loại tiến lên những tầm cao mới. Thế nhưng cũng có không ít thí nghiệm mà sau đó người ta mới nhận ra rằng nó thật điên rồ và ngớ ngẩn. Không những nó không giúp ích gì cho sự phát triển của khoa học mà có khi còn để lại những hậu quả nặng nề...
Đầu ông này cắm cổ bà kia
Thập niên 50 và 60 của thế kỷ trước là thời kỳ vàng son của khoa học. Con người lúc đó đã bắt đầu những chuyến thám hiểm không gian, xem tivi và được nhìn thấy mô hình xoắn đôi đầy quyến rũ của các chuỗi ADN. Năm 1954, ca cấy ghép nội tạng (một quả thận) đầu tiên ở người thành công đã mở ra nhiều hy vọng cho kỹ thuật cấy ghép. Nhưng có lẽ do quá huyễn hoặc vào thành công của mình, các nhà giải phẫu đã nghĩ ngay đến việc ghép... đầu người.
Trước đó đã có hàng trăm con chó và khỉ phải "hy sinh" làm vật thí nghiệm bởi con người luôn bị lôi cuốn bởi ý tưởng giành lại sự sống sau khi bị hành hình bằng máy chém và cũng đã có một vài ca thành công. Tuy nhiên, từ thành công trên động vật đến thành công với cơ thể người còn cả một khoảng cách lớn. Để thực hiện ý tưởng ghép đầu người - mà sau này nhiều tờ báo gọi đó là "hão huyền" và "điên rồ", năm 1985, Viện nghiên cứu Y học ở Kyev (Nga) đã tiến hành ghép đầu một học giả xuất chúng bị ung thư xương giai đoạn cuối ghép vào cổ một tên côn đồ khét tiếng bị hành quyết. Sự kiện này gây tranh cãi lớn trong giới khoa học.
“Yêu” ngoài không gian
Những thí nghiệm ngoài không gian thường khá kỳ lạ, từ việc làm nổ tung những con tinh tinh tội nghiệp khi đưa chúng vào quỹ đạo đến việc chế tạo những bữa ăn siêu nhẹ, siêu nhỏ... và sex ngoài không gian. Năm 2000, nhà thiên văn học Pháp Pierre Kohler đã làm xôn xao các tờ báo khi ông tiết lộ trong cuốn sách của mình - "The Last Mission" - rằng NASA đã nghiên cứu tính khả thi của việc áp dụng 10 tư thế "yêu" trong môi trường trọng lực yếu trên tàu con thoi vào năm 1996. Không chịu kém cạnh, người Nga cũng được cho là đã thực thi các thử nghiệm liên quan đến các "cách thức ghép đôi con người" trên không gian.
Các nghiên cứu về ảnh hưởng của môi trường ngoài không gian đến hệ thống sinh sản của con người có lẽ không có gì mới lạ. Ngay từ những chuyến du hành đầu tiên, người ta đã có những hoài nghi về việc các chuyến bay lên quỹ đạo sẽ ảnh hưởng như thế nào đến khả năng sinh sản của con người. Các nhà khoa học Nga đặc biệt chú ý đến việc mang thai của phi hành gia nữ Valentina Tereshkova vào năm 1964. Sau khi trở về từ quỹ đạo, Tereshkova đã cưới đồng nghiệp của mình là Andreyan Nikolayev và không lâu sau đó đã thụ thai em bé đầu tiên của thế giới có bố mẹ từng bay vào không gian. Đứa con gái của họ đã rất khỏe mạnh.
Rất nhiều tiền đã được chi cho thí nghiệm ngớ ngẩn này nhưng công trình của các nhà khoa học lại chẳng mang lại bao nhiêu lợi ích cho con người. Thế cho nên, giới báo chí mới gọi đó là công trình "ném tiền qua cửa sổ tàu vũ trụ".
Nhưng "siêu" chiến binh
"Chiến binh không ngủ" là một trong những dự án lớn được Lầu Năm góc triển khai từ giữa những năm 50 của thế kỷ trước. Theo đó, để tạo ra những chiến binh không ngủ cả ngày lẫn đêm trong các trận chiến kéo dài, Cục Kế hoạch nghiên cứu cao cấp thuộc Bộ Quốc phòng Mỹ đã cho thử nghiệm modafinil - một loại thuốc có tác dụng kích thích trung khu thần kinh, khiến con người có thể thức liên tục trong 40 giờ liền. Không chỉ có vậy, cơ quan này còn tài trợ cho việc nghiên cứu nhiều biện pháp chống buồn ngủ khác thường như dùng điện từ trường kích thích đại não và tiêu trừ mỏi mệt.
Bên cạnh đó, để tạo cho các chiến binh khả năng tự bảo vệ trong điều kiện môi trường ác liệt, không bị lây bệnh truyền nhiễm, chống lại được những tác động của vũ khí sinh hóa và chịu được độ cao lẫn nhiệt độ cao, Lầu Năm góc còn thử nghiệm một dự án tạo ra bộ áo giáp cho cơ thể. Nếu thành công, các chiến binh sẽ có một số khả năng siêu phàm như bay ở trên cao như chim, lặn sâu dưới nước như sư tử biển...
Tuy nhiên, ước mơ của Lầu Năm góc chưa kịp hoàn thiện thì đã kịp tạo ra không ít binh sĩ bị bệnh tâm thần và stress vì những thí nghiệm điên rồ kể trên.
Vaccin phòng chống vũ khí sinh học
Thời kỳ Chiến tranh Lạnh, lục quân Mỹ đã huy động tổng cộng 2.300 người tham gia thí nghiệm vaccin phòng chống vũ khí sinh học. Sau khi được tiêm loại vaccin này, những người tham gia thí nghiệm nhớ lại khi đó họ đã phải chịu những cơn đau dữ dội kéo dài mấy ngày liền như thể bị ai đó bẻ gãy cột sống, kèm theo là những cơn sốt nóng, sốt lạnh. Các tài liệu mật cũng cho thấy, thí nghiệm trên được tiến hành ở bang Maryland từ năm 1954 tới năm 1973 và đã có nhiều người thiệt mạng.
Tiêm chất phóng xạ vào cơ thể
Khi Chiến tranh Thế giới thứ II sắp kết thúc, các nhà khoa học rất muốn tìm hiểu sâu hơn mức độ nguy hại của các nguyên tố phóng xạ đối với cơ thể người. Ngày 10/4/1945, người ta đã tiêm plutôni vào cơ thể một nạn nhân bị thương do tai nạn ôtô để nghiên cứu cơ chế loại bỏ chất phóng xạ của cơ thể người. Sau này, hơn 400 cuộc thí nghiệm tương tự cũng đã được tiến hành, gồm cả các thí nghiệm trị liệu phóng xạ đối với bệnh nhân ung thư, với lượng phóng xạ đưa vào cơ thể người khác nhau. Cho đến nay, người ta vẫn chưa thống kê được đã có bao nhiêu người trở thành nạn nhân của thí nghiệm này.
Cưỡi xe tên lửa
Trước khi sử dụng tên lửa đẩy đưa du thuyền và người vào vũ trụ, Cơ quan Hàng không vũ trụ Mỹ đã nghiên cứu chế tạo một loại xe trượt giảm áp, có tốc độ lên tới hàng trăm km/giờ. Tham gia vào thí nghiệm với xe trượt giảm áp bắt đầu từ năm 1954 là Đại tá, bác sĩ ngoại khoa John Stamp. Khi tốc độ đạt 1.010km/giờ, Stamp đã phải chịu áp lực tương đương với 35 lần sức hút của trái đất. Hậu quả là Stamp đã bị thương tổn khắp người, không chỉ là việc gãy mất mấy dẻ xương sườn, dập xương cổ tay, bay cả "hàng tiền đạo", mà còn bị vỡ mạch máu ở mắt và chấn động não.
Phun chất độc thần kinh
Mối đe dọa của chiến tranh sinh hóa đã khiến Lầu Năm Góc cho thực thi Kế hoạch 112 vào những năm 1960, 1970. Một trong những nội dung của nó là phun các loại chất độc thần kinh như Sarin, VX lên hàng ngàn, hàng vạn binh sĩ hải quân nhằm kiểm tra trình tự làm sạch độc tố và các biện pháp bảo đảm an toàn. Năm 2002, Bộ Quốc phòng Mỹ đã công khai chi tiết kế hoạch này. Sau đó, Cục quản lý quân nhân về hưu đã cho điều tra về khả năng bị thương tật của các quân nhân tham gia thí nghiệm này.